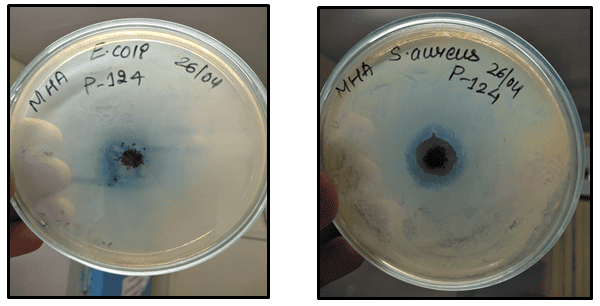

Eco-Friendly Synthesis of Copper Nanoparticles Using Aconitum Heterophyllum Extract and Its Antibacterial Evaluation
DOI:
https://doi.org/10.5281/zenodo.17256020Keywords:
Heterophyllum, Formulations, Copper NanoparticlesAbstract
Copper nanoparticles (CuNPs) were successfully synthesized via an eco-friendly green method using Aconitum heterophyllum extract, which acts as a reducing as well as stabilizing agent. The biosynthesis involved the reaction of copper sulfate with the plant extract in deionized water, forming well-dispersed, uniform, and stable CuNPs. This rapid and cost-effective method is environmentally benign and enhances the functional properties of the nanoparticles. The synthesized CuNPs were characterized using UV-Vis spectroscopy (revealing a distinct absorption peak), high-resolution transmission electron microscopy (HR-TEM) for morphological analysis, and energy-dispersive X-ray spectroscopy (EDX) for elemental composition. Antimicrobial tests confirmed the potent antibacterial activity of the CuNPs, demonstrating significant inhibition zones against both Gram-positive and Gram-negative bacterial strains. This study highlights A. heterophyllum as a sustainable and effective bioresource for CuNP synthesis with promising applications in nanotechnology, biomedical treatment, and antimicrobial formulations.
Downloads
References
Mehdizadeh, T., Zamani, A., & Froushani, S.M.A. (2020). Preparation of Cu nanoparticles fixed on cellulosic walnut shell material and investigation of its antibacterial, antioxidant and anticancer effects. Heliyon, 6, e03528.
Wang, G., Zhao, K., Gao, C., Wang, J., Mei, Y., Zheng, X., & Zhu, P. (2021). Green synthesis of copper nanoparticles using green coffee bean and their applications for efficient reduction of organic dyes. J. Environ. Chem. Eng., 9, 105331.
Akhter, G., Khan, A., Ali, S.G., Khan, T.A., Siddiqi, K.S., & Khan, H.M. (2020). Antibacterial and nematicidal properties of biosynthesized Cu nanoparticles using extract of holoparasitic plant. SN Appl. Sci., 2, 1–6.
Zhao, K., Wang, J., Kong, W., & Zhu, P. (2020). Facile Green synthesis and characterization of copper nanoparticles by aconitic acid for catalytic reduction of nitrophenols. J. Environ. Chem. Eng., 8, 103517.
Sadeghi, B., Rostami, A., & Momeni, S.S. (2015). Facile green synthesis of silver nanoparticles using seed aqueous extract of Pistacia atlantica and its antibacterial activity. Spectrochim. Acta Part A Mol. Biomol. Spectrosc., 134, 326–332.
Guilger-Casagrande, M., & Lima, R. (2019). Synthesis of silver nanoparticles mediated by fungi: A Review. Front. Bioeng. Biotechnol., 7, 287.
Paramanya, A., Sharma, S., Bagdat, R.B., & Ali, A. (2020). Recent practices of medicinal and aromatic plants in nanotechnology. In: Nanomaterials for Agriculture and Forestry Applications, Elsevier: London, UK, pp. 435–467.
D Bhattacharya, & G Rajinder. (2005). Crit Rev Biotechnol., 25, 199-204.
PT Anastas, & JC Warner. (1998). Green chemistry: Theory and practice. Oxford University Press Publishers.
AS Matlack. (2001). Introduction to green chemistry. (3rd ed.). New York: Marcel Decker Publishers, pp. 3-7.
P Mohanpuria, NK Rana, & SK Yadav. (2008). J. Nano Part Res., 10, 507-517.
Khan M, Khan T, Wahab S, Aasim M, Sherazi TA, & Zahoor M, et al. (2023). Solvent based fractional biosynthesis, phytochemical analysis, and biological activity of silver nanoparticles obtained from the extract of Salvia moorcroftiana. PLoS One, 18(e0287080), 1–26,
Published
How to Cite
Issue
Section
License
Copyright (c) 2025 Rupali Nagarekar, Deepika Hasija, Neelam Lohakare, Maheshwari Zirpe, Mahesh Dhaygude, Sobiya Parkar, Mehnaz Barde

This work is licensed under a Creative Commons Attribution 4.0 International License.
Research Articles in 'International Journal of Engineering and Management Research' are Open Access articles published under the Creative Commons CC BY License Creative Commons Attribution 4.0 International License http://creativecommons.org/licenses/by/4.0/. This license allows you to share – copy and redistribute the material in any medium or format. Adapt – remix, transform, and build upon the material for any purpose, even commercially.


